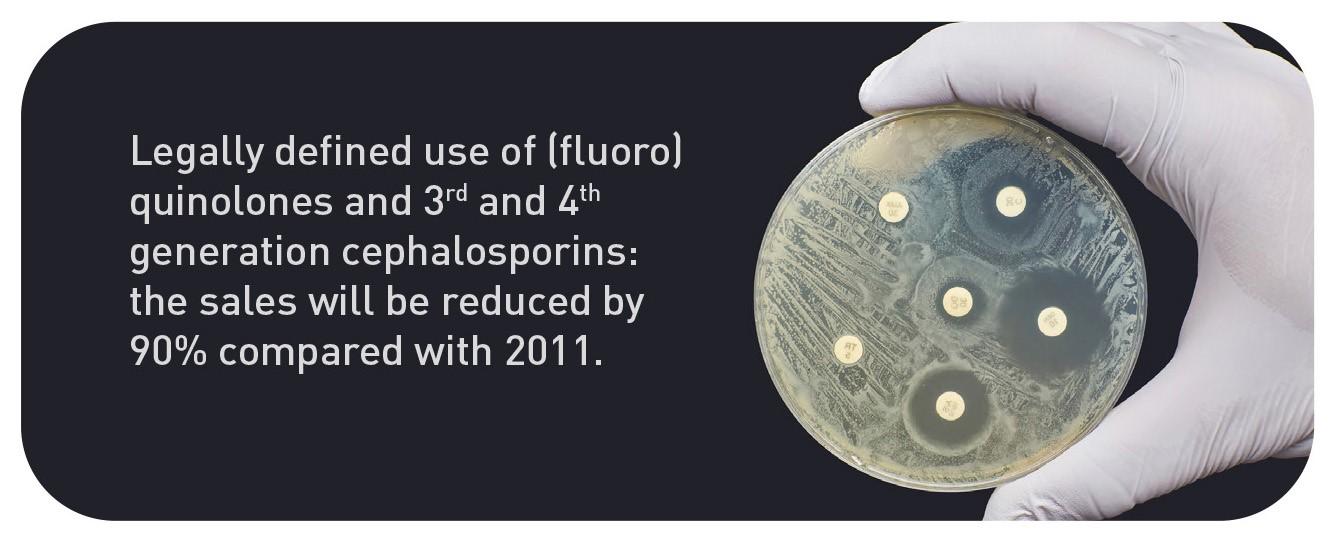

Five objectives





Nine action points
In order to achieve these targets, 9 action points have been laid down in the AMCRA Vision 2030.

In order to achieve these targets, 9 action points have been laid down in the AMCRA Vision 2030.